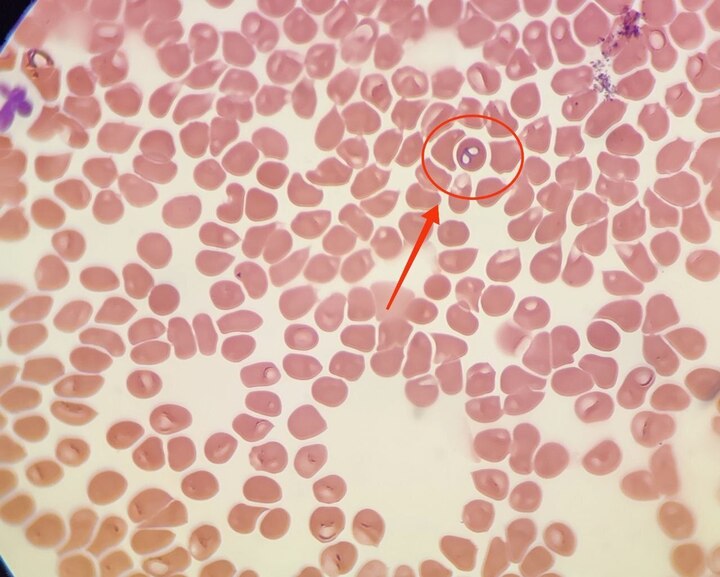

Весной в Чувашии обострилась угроза пироплазмоза у домашних животных
С приходом тёплого сезона активизировались клещи — и это серьёзная опасность не только для людей, но и для домашних животных. Укусы паразитов могут привести к инфицированию пироплазмозом — опасным заболеванием, поражающим эритроциты и вызывающим у питомцев резкое ухудшение состояния.
Ветеринары напоминают: если собака или кошка стали вялыми, отказываются от еды, теряют интерес к играм — не стоит ждать. Необходимо срочно обратиться в ветеринарную клинику и сдать кровь на анализ.
Специалисты Шумерлинского подразделения Чувашской республиканской ветеринарной лаборатории уже обследовали шесть животных за первые месяцы 2025 года. У пяти из них был диагностирован пироплазмоз.
Определить заболевание можно при микроскопии: паразиты обнаруживаются внутри эритроцитов. Чем раньше установлен диагноз — тем выше шансы на успешное лечение и восстановление.
Владельцам домашних животных рекомендуют своевременно проводить обработку от клещей и регулярно проверять питомцев после прогулок.